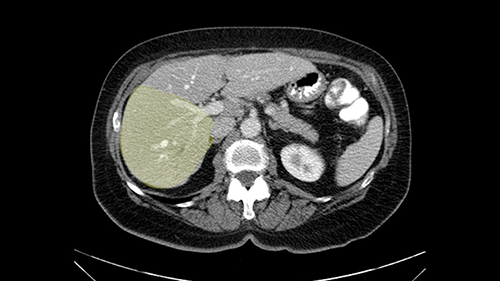

International Hepato-Pancreato-Biliary Association
Right hemihepatectomy (to posterior sectionectomy) [case 13]
Surgeon's Impressions
Watch the following videos of the surgeons preoperative plans for the case. Compare their findings with your own analysis.
Dr. Wei's Procedure-specific moments:
1. Laparotomy for extrahepatic disease
2. Intraoperative ultrasound
3. Check for liver disease
4. Dissection of inflow vessels
5. Avoid common bile duct
6. Mobilization of right liver
7. Right hepatic vein dissection
Dr. Wei's Critical imaging findings:
Review tumor locations on previous imaging
Proximity of tumors to vascular structures
Intrahepatic ductal dilatation in Sg 7
My name is Alice Wei and I’m an associate professor of surgery at the University of Toronto and a hepatobiliary and pancreatic surgical oncologist at the University Health Network. This patient is a 65-year old female who was referred to me with synchronously presenting colorectal liver metastases in Segments 4a, Segment 7, 6 and 5; and I’ve decided to perform a right hemihepatectomy on this patient and in planning this operation there are some procedure-specific and patient-specific slowing down moments.
For me the procedure-specific slowing down moments in a right hemi hepatectomy for this patient include: At the time of exploratory laparotomy, a very careful assessment for extrahepatic disease as this patient is high risk of having additional occult disease not identified on pre-op imaging. In addition, a second procedure-specific slowing down moment would be to have a very careful intraoperative assessment of the patient’s known liver metastases as they are very small and may be hard to see or feel at the time of surgery. So in general, I would have to use intraoperative ultrasound to landmark the tumors and the relationship to surrounding structures. The third slowing down moment would be to have a careful assessment of the non-tumor liver to rule out any chemotherapy-associated liver disease or unexpected liver disease when planning the surgery that she’s about to have.
The procedure-specific slowing down moments from a technical point of view for a right hemihepatectomy include a careful evaluation of the inflow structures including the right hepatic artery, the right portal vein, as well to make sure that I have identified and preserved the left hepatic artery and the left portal vein at all times, and minimize any injury or dissection of the common bile duct. Also, I am careful when I mobilize the right liver, not to tear the right triangular ligament and cause bleeding of the liver as I mobilize it off the retroperitoneum and the bare area. In addition, the last procedure-specific slowing down moment is to carefully identify the right hepatic vein and ensure that I encircle it safely without damaging the IVC or the middle and left hepatic vein structures at all times.
![[LPV]](jpg/preop_aw_moment4d.jpg)
In this patient with multiple synchronous liver metastases that are small in nature, I’m very careful to ensure that I review not just the most recent CT scans but also all of the original CT scans from the time the patient declared with liver metastases so I can locate the original positions of the tumors, I can see the response to chemotherapy, and to ensure that I evaluate all of the areas where the tumors initially were present at the time of surgery to decide whether or not they need to be removed at the time of surgery.
In addition, as I plan this operation, I will also look at the size of the small tumors. They’re very small, some are less than one centimetre in size, and carefully evaluate the relationship between the small tumors and the surrounding vascular structures. If I cannot see or feel the tumors at the time of surgery, I will use the blood vessels in order to landmark and plan my operation.
![[MHV, LHV, RHV]](jpg/preop_aw_moment7.jpg)
The third issue for this patient is that in Segment 7, I notice that there is intrahepatic ductal dilatation due to a small tumor causing obstruction. Now this tumor is not well-visualized on the most recent CT scan but I want to carefully evaluate the bile duct, where the obstruction is, so at the time of surgery I can be sure to remove the affected bile duct as well as the small tumor that is causing the ductal dilatation.
![[before chemo]](jpg/preop_aw_moment8.jpg)
So in light of the CT findings, the plan for this patient is a right hemihepatectomy that would encompass all the small tumors including the one in 4a-8, 5, 6-7; and the reason that I would do a full right hemihepatectomy is because of the intraductal dilatation in Segment 7 that makes me suspicious that there is a tumor that cannot be removed with simple wedge resections.
Dr. Gallinger's Procedure-specific moments:
1. Future liver remnant
2. Hepatic outflow vessels
3. Hepatic artery anatomy
4. Portal vein bifurcation
Patient-specific moments:
Sg 7 branch at right portal vein bifurcation
Divide bile duct in liver
My name is Steven Gallinger, I’m a professor of surgery at the University of Toronto and an HPB surgeon at the University Health Network. I’ve been asked to comment on this case and discuss preoperative planning, potential slowing down moments. It’s an interesting 65-year old woman with right sided colon cancer and synchronous liver metastases: small metastases in the right lobe of the liver and she had the primary tumor resected and then underwent neoadjuvant chemotherapy for her small liver metastases in Segments 4, 5, 6 and 7. The distribution of the metastases is interesting. They are small lesions, but the interesting additional feature is isolated segmental dilatation of the Segment 7 bile duct which suggests an intrabiliary metastasis somewhere near the origin of the main Segment 7 duct. Because I can trace it close to the porta [hepatis], I would assume that it’s pretty close to the bifurcation of the main right sided bile ducts but I can’t actually see the actual tumor. It’s really just presumptive.
She underwent neo-adjuvant chemotherapy and then had a series of additional investigations and the one that I’m focusing on in more finer detail is an MRI with Primovist and I’ve had the benefit of looking at the report. The main issues are in Segments 5,6, and 7. Three small metastases that remain and the radiologist also comments on the lack of biliary dilatation which was present before; implying that the intrabiliary metastasis somewhere at the origin of the Segment 7 duct, has regressed or been adequately well treated with chemotherapy. That’s probably where the difficult decision making comes in the OR. So from an oncologic point of view, I would plan for a right hepatic lobectomy. The rationale would be that this would include the more peripheral Segment 5, 6, 7 metastases that are obvious but also would take care of the presumed Segment 7 intrabiliary metastasis that does not actually visualize on any of the scans but is assumed to be there with evidence of the duct dilatation which then resolved. One could argue whether we should preserve liver and ignore that duct dilatation that was there before but I think my own preference would be to resect the right lobe and that would certainly include any residual disease in that Segment 7 bile duct and moreover, coming back to do a completion right hepatic lobectomy would be difficult particularly around the porta where this metastasis is presumably still there and even if its quite small.

So when doing a major liver resection, obviously we would focus on a few issues. The first is hepatic parenchyma: is there adequate liver, residual liver and orientation and ratio of the right to left lobe here is pretty normal. It looks like its about 60:40 or 70:30, and because its only a right lobe, I probably wouldn’t do any volumes assuming she has normal liver function which I think she does. The only additional feature of interest is that she has received chemotherapy and one can see the effect of chemotherapy on the density of the liver but again, it doesn’t usually cause significant problems with a short course of neoadjuvant chemotherapy, or liver failure.
So I would then focus on the hepatic outflow because that’s the way we do the operation is by mobilizing the liver. So the vena cava looks quite normal. The right hepatic vein looks quite normal. There are no large additional outflow veins from the right lobe which would generate slowing down moments. The hepatic artery is unremarkable and is not usually an issue we can define the anatomy quite clearly at surgery.
![[RHA]](jpg/preop_sg_moment3.jpg)
The only other most important feature that I usually consider is the portal vein split or the bifurcation, especially if doing a major liver resection like a right lobe. I like to look at the length of the common right portal vein trunk which looks like its probably long enough to put a stapler on. Final decision would be in the OR. If it wasn’t long enough and I was concerned about injuring the bifurcation or the left portal vein, then I would divide the Segment 5-8 and 6-7 portal tracks individually.
![[LPV]](jpg/preop_sg_moment4b.jpg)
This patient has an interesting minor anomaly with what looks like a Segment 7 portal vein coming off close to the bifurcation of the right portal vein but again if I was doing a right lobe which is my plan, this wouldn’t be an issue.
![[Sg7 branch]](jpg/preop_sg_moment5.jpg)
Finally the bile duct is divided in the liver. I can actually see this patient’s bile duct. It’s a bit dilated and she had cholecystectomy. I think we would divide the bile duct in the liver. It’s hard to anticipate from a CT scan what you’re going to see because you can’t actually see the bile duct very well on the average CT.
![[Sg7 branch]](jpg/preop_sg_moment6.jpg)
So overall I would plan to do a right hepatic lobectomy. The slowing down moments are the usual ones: carefully mobilizing the right lobe, not injuring the main hepatic veins or the vena cava, the right portal vein split, the length of the right portal vein. The rest looks very routine. The oncologic issue I’ve already decided I’m going to do a right lobe with the assumption that there is an intrabiliary metastasis somewhere near the origin of the right- the Segment 7 duct and probably close to the bifurcation of the main right bile duct so the best way to get a margin is to actually divide the right bile duct close to its origin the way you would normally do a right hepatic lobectomy.
Patient-specific moments:
Examine entire liver
Intraoperative ultrasound
Possible right posterior sectionectomy, 5-8 resection
Hanging maneuvre
Dissection of posterior biliary pedicle
Use guide or contrast to identify hepatic ducts
Pringle maneuvre
ENGLISH TRANSLATION
I am Professor Jacques Belghiti, hepatobiliary surgeon. I practiced at Beaujon Hospital at Paris Diderot University Paris 7. I will discuss the case of a 65-year old patient who has hepatic metastases from a colon cancer operated on one year before. Two particular points with this patient: She has had a cholecystectomy at the time of colectomy, and at the discovery of the lesions in which there were 3, all located in the right liver, we noted the existence of biliary dilatation. This biliary tract dilatation could have been a consequence of the cholecystectomy, or due to a particular form of metastasis with biliary infiltration; and my impression is that the second hypothesis should be supported for two reasons. The first reason is that on the initial CT scan, we had a feeling that the biliary tract dilatation was associated with a small tumor/lesion. The second reason is that the dilatation decreased after several courses of chemotherapy. I don’t know how many courses of chemotherapy she had, but in any case, there exists some lesions of the hepatic parenchyma, with steatosis that may have been a consequence of this chemotherapy. After several courses of chemotherapy, we see at least 2 lesions persisting in the posterior sector of the right liver and dilatation of the biliary tracts. There might be another lesion at the junction of Sg 5 and 8. So this patient should now be operated on since we are faced with lesions that persisted after chemotherapy.
The operation that should be planned, cannot be a usual metastases operation because a feature of metastases, once there is biliary involvement, is that they will be infiltrating lesions that need to be taken out with wide margins. In other words, we cannot envision a local resection. You have to do a hepatectomy.
It’s been a few years, I would have done a right hepatectomy. I think it is more sensible now, especially taking into account the current Japanese and Asian practices, to do a more limited operation. So my option will be a generous hepatectomy by traditional ways. I would not do laparoscopic, not because I don’t think it’s good but because I usually don’t do laparoscopy. By classical sense, a formal hepatectomy, a thorough evaluation of the liver manually, visually, and with intraoperative ultrasound to locate all the areas, notably any scarred tissue that could be left behind from previous metastases that shrunk under chemotherapy. In 90% of cases, even if the lesions are not visible on CT or MRI, they are detectable as a form of scarring that should be seen by ultrasound, and you have to find them after having evaluated on ultrasound or by palpation. If I don’t find any other lesions, I would revise for a posterior sectorectomy, taking out Sg 6 and 7 in a generous fashion to get the biliary involvement, and a local resection of the Sg5-8 lesion.

A posterior sectorectomy is difficult. It’s a technique that would require, in this case, a complete mobilization of the liver. It can be facilitated by a Hanging maneuver that would allow you to pass behind the right [6-7] hepatic vein, but it would be difficult to locate the origin of the right biliary tract because, in general, the origin of the right sectoral biliary tract isn’t found like this, but in general it passes over the anterior sector. So you have to be careful.
It’s an operation with high risk of postoperative bile leak. Very likely, I think to facilitate this operation, if we want to stay with a posterior sectorectomy, I wouldn’t hesitate to put a guide in the biliary tract [duct] to locate the other biliary tracts. In any case, I would re-dissect the cystic duct for injecting contrast. I anticipate difficulty concerning the biliary ducts. Otherwise I think just as you have to dissect well, I think I will do this operation under intermittent pedicle clamping. The goal is not to lose [blood], to not have hemorrhage, but the goal is to have a [bloodless] operative field that is extremely dry in order to locate the biliary tracts, the arterials and the portal system of the posterior sector. Since it’s a bit of a difficult operation, I would lean towards having a preoperative 3D reconstruction.
TRANSCRIPTION EN FRANÇAIS
Je suis le Professeur Jacques Belghiti, chirurgien hépatobiliaire. J’exercais à l’Hôpital Beaujon à l’Université Paris 7. Donc, je vais discuter le cas d’une malade de 65 ans qui a des métastases hépatiques d’un cancer du colon opéré un an auparavant. Deux points particuliers chez cette malade. Elle a eu au cours de la colectomie une cholécystectomie et lors de la découverte des lésions, qui étaient au nombre de 3, situées toutes dans le foie droit, on notait l’existence d’une dilatation des voies biliaires. Cette dilatation des voies biliaires pouvait être soit une conséquence de la cholécystectomie, soit due à une forme particulière des métastases hépatiques avec une infiltration biliaire, et j’ai l’impression que c’est la deuxième hypothèse qui doit être retenue pour deux raisons. La première c’est que sur le scanner initial, on avait l’impression que s’associait à la dilatation de voies biliaires une petite lésion tumorale, et la seconde raison, c’est que cette dilatation ait diminué après plusieurs cures de chimiothérapie. Je ne sais pas très bien combien de cures de chimiothérapie elle a eu mais en tous les cas, il existe des lésions du parenchyme hépatique avec une stéatose qui pourrait être la conséquence de cette chimiothérapie. Après plusieurs cures de chimiothérapie, on voit persister au moins deux lésions dans le secteur postérieur du foie droit et la dilatation des voies biliaires. Peut-être une autre lésion à la jonction du 5 ou du 8. Alors cette malade doit donc maintenant être opérée puisqu’on est face à des lésions qui persistent après chimiothérapie.
L’opération qui doit être prévue ne peut pas être une opération habituelle des métastases car la caractéristique des métastases lorsqu’elles entrainent une atteinte biliaire, c’est qu’il s’agit de lésions infiltrantes qui nécessitent de passer au large. C’est à dire qu’on ne peut pas envisager des résections locales. Il faut faire une hépatectomie.
Il y a quelques années, j’aurais fait une hépatectomie droite, mais je pense qu’il est plus raisonnable maintenant surtout à la lumière des expériences japonaises, asiatiques de faire des opérations plus limitées. Et donc mon option sera une large hépatectomie par voie classique. Je ne ferais pas, non pas parce que je ne pense pas que c’est bien, mais parce que j’en ai pas d’habitude, je ne ferais pas de laparoscopie, par voie classique une large hépatectomie, une exploration complète de tout le foie manuelle, visuelle et à l’ échographie peropératoire de façon à repérer toutes les zones notamment les zones cicatricielles qui pouvaient être la conséquence de précédentes métastases qui ont diminué sous chimiothérapie. Dans 90% des cas, même si les lésions ne sont pas visibles, en scanner ou à l’IRM, elles sont décelables sous la forme de cicatrices qu’il faut enlever à l’échographie, et qu’il faut enlever après avoir exploré à l’échographie ou à la palpation. Donc je m’orienterais, si je ne découvre pas d’autres lésions, vers une sectoriectomie postérieure enlevant le 6, le 7 de façon à passer au large, d’avoir de l’atteinte biliaire et une exérèse locale de la lésion du 5 et du 8.

La sectoriectomie postérieure est difficile. C’est un technique qui va nécessiter, dans ce cas là, un mobilisation complète du foie. Elle pourrait être aidée par une manoeuvre de Hanging qui permettra de bien passer en arrière de la veine sus-hépatique droite, mais la difficulté va être de repérer l’origine de la voie biliaire sectorielle droite car en général, l’origine de la voie biliaire sectorielle droite ne se fait pas comme ça, mais en général elle passe par dessus la sectorielle antérieure. Donc il faudra faire attention.
C’est une opération à haut risque de fuite biliaire post-opératoire. Très probablement, je pense que pour faciliter cette opération, si on veut rester dans la sectoriectomie postérieure, je n’hésiterais pas à mettre un guide dans la voie biliaire pour repérer les autres voies biliaires. En tous les cas, je redisséquerais le cystique pour faire une opacification. Je m’attends à des difficultés sur le terme biliaire. Sinon, je pense justement que comme il faudra bien disséquer, je pense que je ferais cette opération sur clampage pédiculaire intermittent. Le but c’est pas de perdre, de ne pas avoir d’hémorragie, mais le but c’est d’avoir un champ opératoire extrêmement sec pour bien repérer les voies biliaires, les voies artérielles et les voies portales du secteur postérieure. Comme c’est une opération un peu difficile, je m’orienterais vers une reconstruction 3-D préopératoire.
Patient-specific moments:
Biliary dilatation
Inspect lymph nodes at hepatoduodenal ligament
Hello my name is Ajith Siriwardena. I’m a professor of hepatobiliary surgery at The Manchester Royal Infirmary in England. The case I’m going to talk about today is a lady with colorectal hepatic metastases.
So what we want to know is, we need to know the answer to 3 questions: what is the general extent of the disease, what is the local distribution and is the disease resectable?
And the patient that we see here is a 65-year old lady who presented with a bowel cancer and had a bowel resection. We know that once bowel cancer has spread to the liver, it’s probably best considered as a systemic disease with local regional manifestations and the treatment option needs to combine systemically directed treatments with local regional treatments. So you can give chemotherapy before and after the resection. So she would typically have had probably somewhere between 3 and 6 cycles of a neoadjuvant chemotherapy.
So now we’ve assessed extent of metastatic disease, we’ve got some idea of fitness. The last item and I put it third because it’s actually the easiest of the three is what is the extent of the disease within the liver. For that we use contrast-enhanced magnetic resonance scanning, contrast-enhanced MR good for planning treatment.
I look at this in two ways: first of all, I’m going to make an assessment of the distribution of the lesions and second, I’m going to say what major inflow/outflow structures will I need to deal with in order to resect the tumor. It’s very easy. So distribution of disease, inflow/outflow structures.
So we’re starting down here: right kidney Segment 6, and you can see there is a first lesion there. It’s probably in 5. I can’t say definitively just yet. That’s the lesion at the back it’s probably in Sg6.
Coming up a little bit higher. There’s a little bit of biliary dilatation as well. On the right side of the liver. Which may be nothing but it may be an indicator or harbinger of nodal disease in the hepatoduodenal ligament so something to be aware of. If the enzymatic liver function tests are normal and there’s no evidence of a stone in the common bile duct on cross sectional imaging you wouldn’t need to do anything about it but just to be aware of that.![[RHV]](jpg/preop_as_p4.jpg)
So we’re going through the liver segments now. Here we’ve got the inflow; here’s the main portal vein, right anterior sectoral portal vein, right posterior sectoral portal vein there. Here’s the main here going to the left lobe first of all. So that’s 3 and 2 there, they look clear, and there’s a good size of the left lobe with a good girth. So 3 and 2 look clear. There are usually more feedback branches from the left portal vein to segment 4b but that also looks relatively clear. There’s a little more disease over on the right side there. So that would be...right hepatic vein here...that’s Segment 7. So we’ve got disease in 7, 5, probably in 6 on the right side; at least 3 lesions. That’s the distribution of the lesions.![[Ant. RPV] [Main PV] [Post. RPV]](jpg/preop_as_p5.jpg)
So look at the MR from two points of view, firstly distribution of the lesions, secondly what kind of parenchyma would need to be resected to remove that disease and what kind of operation would we plan. And again so what we’re planning here would probably be a right hepatectomy. We know that there is plenty of disease-free left lobe. Segment 4 looks nice and clear. So a transection line coming down to about that kind of area would clear all of the disease. So that’s the kind of preoperative planning that we’d need to do.
If we go on to the technical aspect of doing that, you could do that laparoscopically, you can do that open. Essentially the principles of surgery for laparoscopic or open right hepatectomy are the same. So here let’s talk about this as an open right hepatectomy.
In this case, with this specific case, one of the things that I was a little concerned about was that biliary dilatation because biliary dilatation isn’t normally part of the kind of landscape of metastatic colorectal cancer unless there are lymph nodes enlarged in the hepatoduodenal ligament. So I would, in this case, I would specifically look at the hepatoduodenal ligament to see whether she’s got enlarged lymph nodes. If they’re enlarged and they spread all the way down, if there’s a chain of enlarged lymph nodes running behind the back of pancreas, that can be seen as contraindication to liver resection because it means that there’s regional metastatic disease which isn’t going to be resected by a liver resection. So that biliary dilatation is a little bit of a source for concern. The other thing is that there is a way of predicting how patients will do from liver resection. Quite often referred to as the Fong Score. Here, there are more than one metastases, 3 or 4 metastases. So that’s the one point that’s beginning to indicate that maybe the prognosis is a little worrying but it wouldn’t stop you doing a resection. A resection would be an appropriate thing to do here.

There is a very specific technique known as the anterior approach with liver hanging, which I haven't talked about here. I’m talking about conventional standard technique of right hepatectomy which involves mobilization of the liver to come out. So that the liver is mobilized away from the cava because caval injury during liver resection is one of the most feared complications of liver surgery.
Then we have intraoperative ultrasonography to look at the distribution of the disease in the liver that's coming out but make sure that there’s no unsuspected metastatic disease in the hemiliver that's staying behind. Then we have inflow control, outflow control. The liver has to be mobilized from the cava. Those three steps depends a little bit on the sequence in which you want to do them. I tend to do mobilization of the liver from the cava as the first of those three steps. That runs into getting outflow control without outflow ligation. Then I do inflow control and then I do transection. The reason why I do that is that I really want to have that liver mobilized off the cava so that I know the extent of what my transection is going to be.
If I need to control the right inflow pedicle, I’ll take the gallbladder dissection down to nicely show the right hepatic ducts so I know where the right hepatic duct is. Look behind the right hepatic duct, always you have the right hepatic artery there so right hepatic artery can be divided between right angle forceps, divided and ligated. Once that’s done, the only structure behind you is the right portal vein. If you use an eyelid retractor or Desmarres forceps just to hold the bile duct up, you see the main portal vein, you’ll probably see some caudate branches, and then you see what I call the ‘hammerhead’ of the portal vein bifurcation. It's a very distinctive, very constant landmark: right portal vein, left portal vein. We can then encircle the right portal vein and quite often it’s sufficient in right hepatectomy for this sort of situation to ligate it in continuity. It definitely doesn't need a big vascular stapler in there because what you don’t want to do when you’re closing the right portal vein is to compromise the left. So I will encircle the right portal vein, I’ll move the forceps just a little bit away from the confluence, be sure that I’m absolutely not compromising the left portal vein and tie it with an absorbable suture. I’m going to staple it within the liver. Now then we’re at a situation where we can come to do transection. You can do transection in one of very many different methods. All of which are probably equal.
If transection is done with the CUSA or with a sealant device, the principles are pretty much the same, which is that if you get bleeding during the transection, fix it. If you spot a bile leak during the transection, fix it because the best time to spot it and fix it is when you first see it.
If during the transection, one thing I didn’t mention in all this, is the use of Pringle maneuvers. you don’t typically need Pringle maybe apart from a few minutes at the depth of that, I don’t routinely use it. I always have it placed for open major surgery because you don’t know when you might need it but if you’re in the depths of the transection and you have some bleeding and it's difficult to control, application of the Pringle maneuver, application of inflow control is the way to control that.
About halfway through that transection, I'll make a call about whether the right hepatic vein needs to go. If it does I’ll take a vascular stapler to take that and then we’re out.
Once the specimen is out, final inspection to make sure there's no hemorrhage and there’s no bile leak. I actually usually check the pulsation into the left hemiliver to make sure that that’s okay. You can use a cut surface sealant. The widely used, there’s no randomized trial evidence suggesting that there’s any given one which is superior to any other, or in fact that any of them make any difference whatsoever. But most surgeons seem to like to use some kind of cut surface sealant on the liver. Then the question of an abdominal drain. By and large, you don’t need a routine abdominal drain. We’ve moved away from using routine abdominal drains after liver resection.
Acknowledgements
Thank you to the HPB Surgeons who contribute their time and expertise. This content is made possible through educational grants from:
Case 28

Views and opinions expressed in all videos and module content are those of the individual surgeon and solely intended for surgical education purposes. We do not endorse any product, treatment or therapy.
Corporate Partners
If you are interested in becoming a Corporate Partner of the IHBPA please contact industry@ihpba.org
Find out more
Go to myHPB
